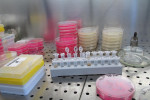
Image

Ένας γιατρός, μία μαία, και διασώστες του ΕΚΑΒ στις Σέρρες έδρασαν καθοριστικά για την υγεία μιας μητέρας και ενός νεογέννητου.
Η περιπέτεια ξεκίνησε όταν η ετοιμόγεννη γυναίκα πήγε στο Κέντρο Υγείας Ηράκλειας με τους γιατρούς να δίνουν εντολή να διακομισθεί με ασθενοφόρο του ΕΚΑΒ και με συνοδεία γιατρού, νοσηλευτή και μαίας στο Γενικό Νοσοκομείο Σερρών.
Κατά τη διάρκεια της διακομιδής, όμως, ο γιατρός και η μαία προχώρησαν αναγκαστικά στη διαδικασία του τοκετού και το μωρό γεννήθηκε μέσα σε αυτό.
Το μωρό, σύμφωνα με πληροφορίες της ΕΡΤ, παρουσίασε συμπτώματα κυάνωσης και προβλήματα αναπνοής με τον γιατρό, τη μαία, τον νοσηλευτή και τους διασώστες του ΕΚΑΒ να δίνουν μάχη για να το κρατήσουν στη ζωή.
Όταν το ασθενοφόρο έφτασε στο Νοσοκομείο το μωράκι επανήλθε και ακούστηκε το κλάμα του. Στη συνέχεια το νεογέννητο μπήκε σε θερμοκοιτίδα που παρακολουθείται από τους παιδιάτρους, ενώ δεν αποκλείεται λόγω προωρότητας να μεταφερθεί σε νοσοκομείο της Θεσσαλονίκης.